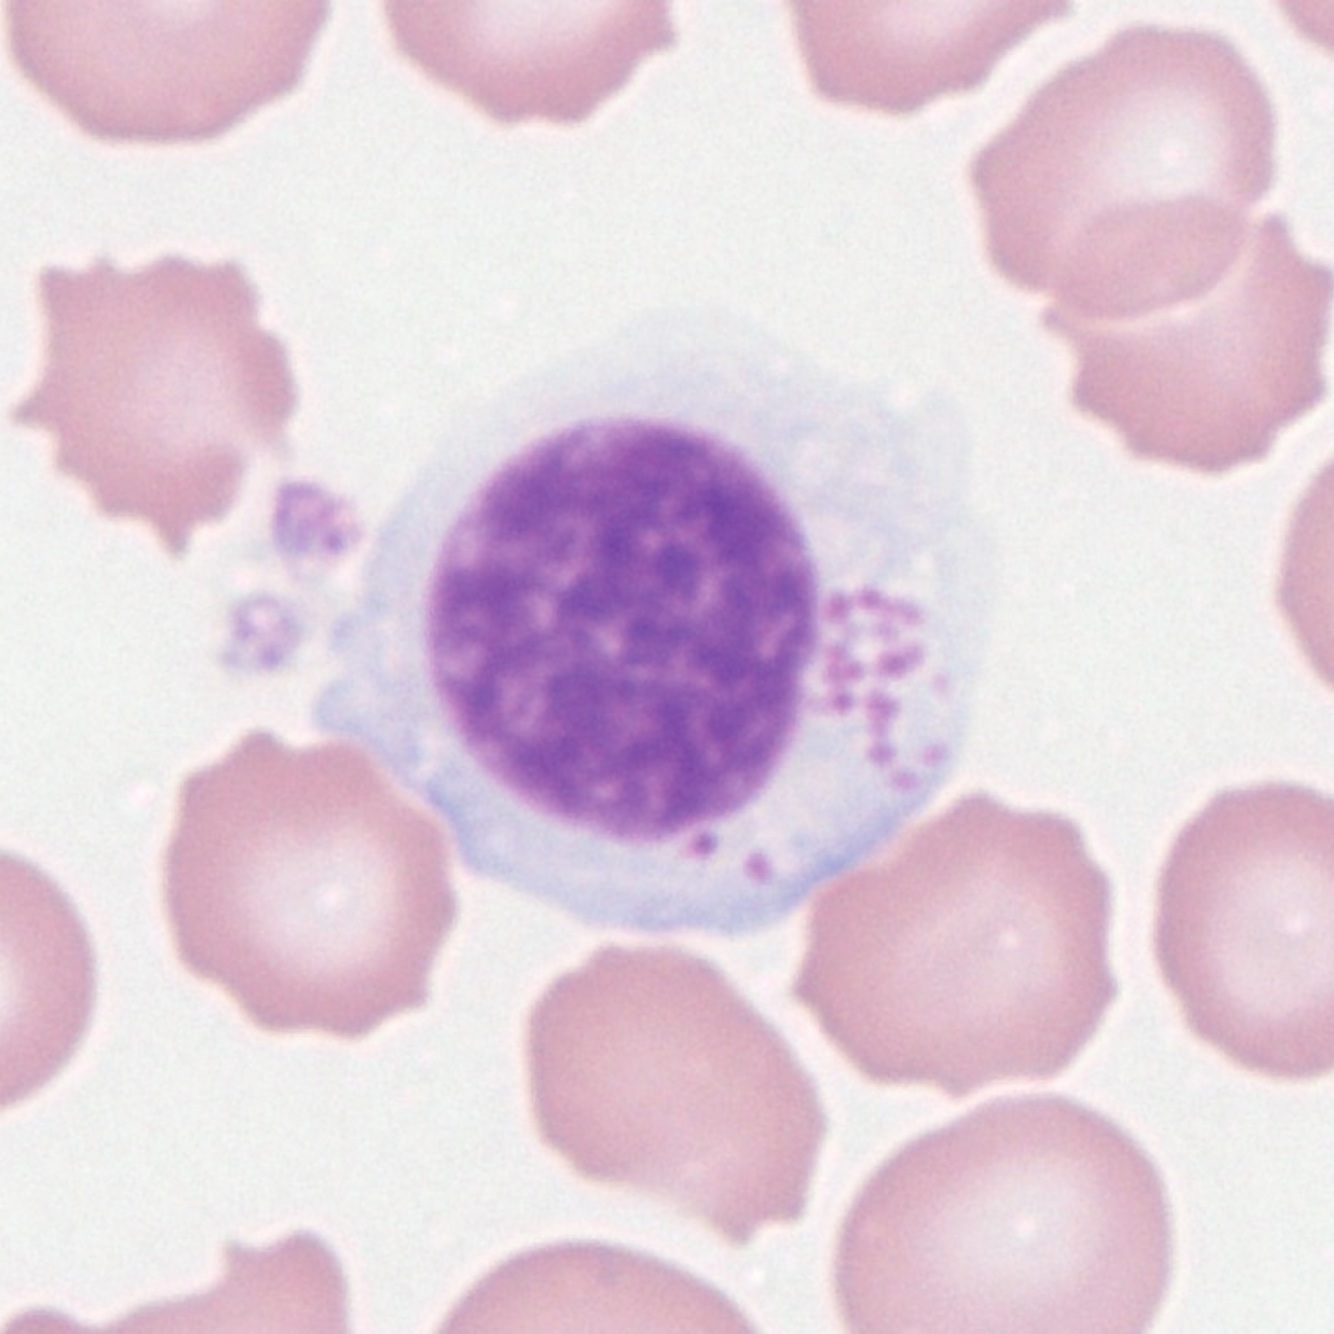

Innate VS Adaptive Immunity

Describe neutrophils.
Location: Blood
Life span: 48-72 hrs
Function: antimicrobial
Action: phagocytosis, degranulation, trap formation

Describe eosinophils.
Location: Blood, GI tract, airways
Life span: Days to weeks
Function: antiparasitic, antiviral, allergy
Action: degranulation, phagocytosis

Describe basophils.

Location: blood
Life span: days
Function: inflammation
Action: degranulation
Describe mast cells.
Location: tissue (CT around vasculature/nerves) & lamina propria of mucosa
Life span: weeks to months
Function: immune surveillance, mediator, amplifies inflammation & allergy
Action: detects threats, degranulation (vasoactive amines) or synthesis of lipids & cytokines

Describe macrophages.
Location: peripheral tissue
Life span: months
Function: immune surveillance, antimicrobial, antigen presentation
Action: detect threats, release inflammatories, phagocytosis

Describe dendritic cells.
Location: tissues
Life span: months
Function: immune surveillance, antigen presentation
Action: detect threats, release inflammatory, endocytosis & phagocytosis

Describe NK cells.
Location: blood, spleen
Life span: months
Function: destroy virally infected or abnormal (tumor) cells
Action: cytotoxic granules
Describe lymphocytes.
Location: blood tissues, secondary lymphoid organs
Life span: weeks, months, years (memory cells)
2 types = T & B cells
Describe cytokines.
-proteins
-cell growth, activation
-interleukins = communication
-chemokines = chemotaxis
Describe the complement system.
-plasma proteins that acts as signaling molecules to recruit immune cells to inflammatory sites
-attacks cell membrane = cell death
-classical (adaptive), lectin, alternative pathways


